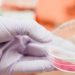
Ελληνίδα επικεφαλής σε σημαντική μελέτη που αποκαλύπτει νέα διάγνωση για τη νόσο Αλτσχάιμερ

Μετά την αναπαραγωγή από την Εφημερίδα σας του ψευδούς και συκοφαντικού σε βάρος εμού και της οικογένειάς μου δημοσιεύματος της Εφημερίδας Documento της 3ης/9ου/2017 του δημοσιογράφου Μάκη Νοδάρου, σας καλώ να δημοσιεύσετε άμεσα στο αυριανό σας φύλλο την εξώδικη απάντησή μου, προς αποκατάσταση της βλάβης που μου προξενήσατε, άλλως θα προβώ στα νόμιμα .
«….ΕΝΩΠΙΟΝ ΚΑΘΕ ΑΡΜΟΔΙΟΥ ΔΙΚΑΣΤΗΡΙΟΥ ΚΑΙ ΠΑΣΗΣ ΑΡΧΗΣ
ΕΞΩΔΙΚΗ ΔΙΑΜΑΡΤΥΡΙΑ –ΔΗΛΩΣΗ -ΠΡΟΣΚΛΗΣΗ
Γεράσιμου (Μάκη) Παρασκευόπουλου του Αγγέλου, πρώην Δημάρχου Πύργου, πρ. δικηγόρου, κατοίκου Πύργου, οδός Γκοτσίνα 14
ΚΑΤΑ
1.Της Εφημερίδας DOCUMENTOMEDIA που εδρεύει στην Αθήνα (Λ. Συγγρού αρ 146) και εκπροσωπείται νόμιμα.
- Κωνσταντίνου Βαξεβάνη του Χριστόφορου, Διευθυντή της εφημερίδας Documento, Λεωφόρος Ανδρέα Συγγρού 146, Καλλιθέα Αττικής 17671
- Γεράσιμου (Μάκη) Νοδάρου του Νικολάου, δημοσιογράφου, κατοίκου Λεχαινών Ν.Ηλείας.
Κύριοι,
Στο φύλλο της 3ης Σεπτεμβρίου 2017 της εφημερίδας documento, της οποίας εκδότης είναι η πρώτη από εσάς εταιρία DOCUMENTOMEDIA και Διευθυντής είναι ο δεύτερος από εσάς Κώστας Βαξεβάνης, στη σελίδα 20, δημοσιεύεται ολοσέλιδο άρθρο που υπογράφεται από τον τρίτο από εσάς δημοσιογράφο Μάκη Νοδάρο με τίτλο: « Μπίζνες με οικογένεια και offshore στον Πύργο», και υπότιτλο: «Πρόσωπο της αγοραπωλησίας ένας πολιτικός, ο τότε δήμαρχος Μάκης Παρασκευόπουλος».
Στο άρθρο αυτό, που είναι γραμμένο με τη γνωστή μέθοδο των θρασύδειλων, αναφέρονται μια σειρά από γεγονότα, που δήθεν παρατίθενται με τη μορφή ερωτημάτων και αποριών, αλλά εμμέσως και σαφώς διατυπώνουν απόλυτα ψευδείς και συκοφαντικούς ισχυρισμούς για το πρόσωπό μου και την οικογένειά μου, με σκοπό να πλήξουν την κοινωνική, επαγγελματική και πολιτική τιμή και υπόληψή μας.
Ειδικότερα κάτω από τον τίτλο «Μπίζνες με οικογένεια και offshoreστον Πύργο», και τον υπότιτλο «Πρόσωπο της αγοραπωλησίας ένας πολιτικός, ο τότε δήμαρχος Μάκης Παρασκευόπουλος» στο άρθρο υπονοείται με σαφήνεια ότι, κατά την περίοδο που ήμουν δήμαρχος ενεπλάκην σε « περίεργες » μπίζνες αγοράς ακινήτου, χρησιμοποιώντας ως παρένθετα πρόσωπα τη σύζυγό μου και μια «offshore» εταιρία που συνέστησα για το λόγο αυτό. Επίσης υπονοεί με σαφήνεια ότι υπήρξε ύποπτη σχέση – συναλλαγή μεταξύ του ενός των πωλητών, ο οποίος είχε εκτελέσει ένα δημοτικό έργο κατά την διάρκεια της οκταετούς θητείας μου, και εμού.
Επειδή οι παραπάνω έμμεσοι πλην σαφείς ισχυρισμοί είναι αυταπόδεικτα στο σύνολό τους κατάφωρα ψευδείς και συκοφαντικοί , το δε άρθρο συνειδητά συντάχθηκε, εν γνώσει της αναλήθειας των ισχυρισμών, με σκοπό να πλήξει την τιμή και την υπόληψή μας, και ενδεχομένως ως μέσο πίεσης εν όψει της δίκης της 8ης Σεπτεμβρίου 2017 στο Α΄ Τριμελές Πλημ/κείο Αθηνών, όπου εκδικάζεται η μήνυσή μου σε βάρος του δεύτερου από εσάς Κων/νου Βαξεβάνη και τρίτου από εσάς Γεράσιμου Νοδάρου για το αδίκημα της συκοφαντικής δυσφήμησης δια του τύπου που διαπράξατε σε βάρος μου και παραπέμπεσθε και οι δύο ως κατηγορούμενοι .
Η αλήθεια έχει ως εξής: Με το υπ’ αρ.446/2011 συμβόλαιο η σύζυγός μου, επιτυχημένη μαχόμενη δικηγόρος επί είκοσι επτά έτη, αγόρασε το ½ εξ αδιαιρέτου ενός αγροτεμαχίου συνολικής έκτασης 4.973,55 τ.μ. στη θέση Παλιοβόρι της δ.κ. Σκαφιδιάς Πύργου Ηλείας. Από την έκταση αυτή, τμήμα 2677,30 τ.μ βρίσκεται εντός οικισμού και τμήμα 2296,25 τ.μ. βρίσκεται εκτός. Το τίμημα για το ½ εξ αδιαιρέτου ήταν 115.000 €. Το έτερο ½ εξ αδιαιρέτου αγόρασε με το υπ’ αρ. 445/2011 συμβόλαιο για λογαριασμό της οικογενείας του ο οικογενειακός μας φίλος, Ελληνοκύπριος, Γιώργος Οικονόμου, γνωστός και έγκριτος δικηγόρος με γραφείο στην Αθήνα ,στην οδό Κ. Κανάρη αρ. 11, μέλος του Ινστιτούτου Διεθνών Διαιτησιών με εξειδίκευση σε διεθνείς κι εγχώριες διαιτησίες, ναυτιλιακό δίκαιο κτλ. Στην άνω έκταση μπορεί να οικοδομηθούν νόμιμα δύο κατοικίες ως χωριστές κάθετες ιδιοκτησίες με δόμηση 200 τ.μ. η κάθε μία. Ο κ. Γεώργιος Οικονόμου είναι σύζυγος γνωστής Πυργίας και διαμένουν μεγάλα χρονικά διαστήματα στην οικία τους στον Πύργο διατηρώντας στενούς δεσμούς με την περιοχή. Με την οικογένεια Γ .Οικονόμου μας συνδέει πολυετής οικογενειακή φιλία. Για την αγορά του ½ εξ αδιαιρέτου ο κ. Οικονόμου συνέστησε νομιμότατη κυπριακή εταιρία περιορισμένης ευθύνης, την Fradica Holdings Limited, η οποία εδρεύει στην Λεμεσό Κύπρου και η οποία δεν είναι οffshore, αλλά ευρωπαϊκή εταιρία, υποκείμενη πλήρως στους ελέγχους και τη φορολόγηση της Ελληνικής Πολιτείας. Σήμερα η εταιρία αυτή, επομένως και το αγορασθέν από αυτή ½ εξ αδιαιρέτου του αγροτεμαχίου, ανήκει στον κ. Αλέξιο Δημήτριο Οικονόμου του Γεωργίου, γυιό του Γιώργου Οικονόμου και επίσης γνωστό και έγκριτο δικηγόρο της Κύπρου στην πόλη της Λεμεσού. Σας επισυνάπτω σχετικό πιστοποιητικό του Υπουργείου Εμπορίου της Κυπριακής Δημοκρατίας. Τα χρήματα για την αγορά αυτή καταβλήθηκαν στους δύο πωλητές, κ. Μάριο Αναστόπουλο και Παναγιώτη Κρεκουκιώτη, συνιδιοκτήτες κατά το ½ εξ αδιαιρέτου, με τραπεζικές επιταγές, τόσο από την σύζυγό μου με επιταγές της Τράπεζας EFG Eurobankergasias, μία για κάθε πωλητή, όσο και από τον οικογένεια του Γ. Οικονόμου, με επιταγές της Τράπεζας Άλφα Μπάνκ, με χρήματα που προήλθαν από την Κύπρο.
Το συμβόλαιο της συζύγου μου συνέταξε η συμβολαιογράφος που αναπλήρωνε την κόρη μου, μετά από νόμιμη αναπλήρωση από το Πρωτοδικείο Αμαλιάδας , διότι η κόρη μου δεν μπορούσε να συντάξει το συμβόλαιο λόγω της συγγένειάς της με την σύζυγό μου. Το δε έτερο συμβόλαιο συνέταξε η κόρη μου καθόσον ο κ. Οικονόμου απευθύνθηκε στην συμβολαιογράφο κόρη μου για τη σύνταξη του συμβολαίου.Ποιο λοιπόν είναι το ύποπτο και περίεργο !!! ,το να αγοράζει η σύζυγός μου και ο οικογενειακός μας φίλος ένα ακίνητο και να απευθύνονται στην συμβολαιογράφο κόρη μου για τη σύνταξη του συμβολαίου.
Ο σύζυγος της κόρης μου, δικηγόρος Πατρών, που σύμφωνα με το δημοσίευμα είχε την «ατυχία» να είναι γυιός ανώτερου δικαστικού, εκπροσώπησε ως δικηγόρος κατά την υπογραφή του αγοραπωλητηρίου συμβολαίου την άνω εταιρία και υπέγραψε το σχέδιο του συμβολαίου μαζί με τον κ. Γιώργο Οικονόμου, δικηγόρο.
Οι δύο πωλητές είχαν αναθέσει την πώληση του ακινήτου τους σε μεσιτικό γραφείο και η μεσίτρια, κα Ολυμπία Βλαχαντώνη , που κι αυτή είχε την «ατυχία» να είναι στέλεχος της Ν. Δημοκρατίας, διαπραγματευόταν για μεγάλο χρονικό διάστημα την πώληση, κι έφερε σε επαφή τους πωλητές με τους αγοραστές.
Ο Πολιτικός Μηχανικός κ Βασ. Παναγόπουλος υπέγραψε την βεβαίωση ότι στο ακίνητο αυτό δεν υπάρχει κτίσμα, δεν υπάρχει αυθαίρετη κατασκευή και δεν έχει εγκατασταθεί αυθαίρετη χρήση, κι είχε κι αυτός την «ατυχία» να είναι φίλος μου και Αντιδήμαρχος στο Δήμο Πύργου.
Τέλος, ο ένας από τους δύο πωλητές ,ο κ .Παναγιώτης Κρεκουκιώτης γνωστός Πυργιώτης, είχε κι αυτός την «ατυχία» να είναι πολιτικός μηχανικός, και εργολάβος δημοσίων έργων και να μειοδοτήσει, ως μέλος κοινοπραξίας, σε ανοικτό δημόσιο διαγωνισμό του Δήμου Πύργου και να εκτελέσει άψογα ένα και μοναδικό έργο που εκτέλεσε κατά την διάρκεια της οκταετούς θητείας μου, προϋπολογισμού 341.000 € , αν θυμάμαι καλά, μείον την έκπτωση που επιτεύχθηκε κατά την διαδικασία του διαγωνισμού είχε πιθανολογούμενο εργολαβικό κέρδος περί τις 50.000 -60.000 ευρω (και όχι 481.000 € ,όπως ψευδώς και σκόπιμα αναφέρει το δημοσίευμα ότι δήθεν έλαβε ως εργολαβική αμοιβή από το Δήμο Πύργου ).
Αυτά είναι τα αληθινά δεδομένα της υπόθεσης. Δεδομένα που αποδεικνύονται από δημόσια έγγραφα και δεν επιδέχονται καμιά αμφισβήτηση .
Όμως αυτά τα δεδομένα διαστρεβλώνονται από εσάς στο συγκεκριμένο άρθρο και διανθίζονται με ψευδή, ανέντιμα και ανήθικα υπονοούμενα, με πρόθεση να δημιουργήσετε στους ανυποψίαστους, χιλιάδες αναγνώστες της πόλης του Πύργου, της Αμαλιάδας αλλά και ολόκληρης της χώρας, την εσφαλμένη εντύπωση ότι κάτι παράνομο και ανήθικο κρύβεται πίσω από τις αγοραπωλησίες αυτές, ότι εμμέσως πλην σαφώς ότι εγώ είμαι το πρόσωπο που αγόρασε την άνω έκταση, ότι τάχα έχω συστήσει offshore εταιρεία, ότι η αγορά ήταν ύποπτη και γι’ αυτό χρησιμοποίησα ως παρένθετα πρόσωπα τους αγοραστές .
Επειδή από την δημοσίευση του άρθρου αυτού, το οποίο διαβάστηκε από χιλιάδες αναγνώστες σε όλη την ελληνική επικράτεια και εκτός συνόρων, όπου κυκλοφορεί η εφημερίδα σας, η οποία μάλιστα στο τεύχος της 3ης/9ου/2017 είχε αυξημένη κυκλοφορία λόγω του ενδιαφέροντος που είχε προκαλέσει και η δημοσίευση στο ίδιο φύλλο του άρθρου του Πρωθυπουργού Αλ. Τσίπρα, θίξατε βάναυσα την κοινωνική, επαγγελματική και πολιτική τιμή εμού και της οικογένειάς μου. Εμού ως ατόμου και επαγγελματία δικηγόρου επί 40 έτη, αλλά και ως επωνύμου προσώπου της δημόσιας και πολιτικής ζωής του τόπου τόσο στα όρια του δήμου Πύργου, όπου εργάστηκα ως δικηγόρος και διετέλεσα Δήμαρχος Πύργου επί δύο συνεχόμενες θητείες από το 2007 έως το 2014 με εκλογή από την πρώτη Κυριακή με ποσοστό 49,5 % και 52 %, όσο και στην ευρύτερη περιοχή του Ν. Ηλείας και την Περιφέρεια Δυτικής Ελλάδας όπου είμαι Περιφερειακός Σύμβουλος αλλά και στην περιφέρεια των Αθηνών και σε ολόκληρη την Ελληνική Επικράτεια ως πρόσωπο που ασχολήθηκα με τη δημόσια πολιτική ζωή από το 1967 ως σήμερα, με επώνυμη πολιτική δράση και θέση τόσο στα χρόνια του αντιδικτατορικού αγώνα στην Ελλάδα και στο εξωτερικό, ως κεντρικό στέλεχος αντιδικτατορικών οργανώσεων με συνέπειες την σύλληψη και φυλάκισή μου και την υποβολή μου σε βασανιστήρια στο ΕΑΤ-ΕΣΑ όσο και στη συνέχεια και μέχρι σήμερα ως στέλεχος δημοκρατικών κομμάτων και υποψήφιος βουλευτής στο Συνασπισμό και στο ΠΑΣΟΚ και ως υποψήφιος αντιπεριφερειάρχης Ν.Ηλείας, χωρίς ποτέ να διατυπωθεί εναντίον μου ίχνος μομφής για την ηθική και την εντιμότητά μου.Της δε συζύγου μου, Κρινιώς Τσάφα , ως ατόμου και επαγγελματία δικηγόρου που επί 27 χρόνια μάχεται με ηθική, εργατικότητα και εντιμότητα, έχοντας κατακτήσει μια ζηλευτή θέση στον στίβο της μαχόμενης δικηγορίας τόσο στα Πρωτοδικεία της Αμαλιάδας και του Πύργου όσο στην ευρύτερη περιφέρεια του Εφετείου Πατρών.
Από πότε η δημιουργία και η απόκτηση ενός ακινήτου από έναν σκληρά εργαζόμενο επαγγελματία είναι ύποπτη !!!
Για τους λόγους αυτούς
Διαμαρτύρομαι έντονα για το απαράδεκτο, κακοήθες ,ψευδές και συκοφαντικό άρθρο σας και
Σας καλώ να προβείτε αμέσως στην αποκατάσταση της βλάβης που μας προκαλέσατε δημοσιεύοντας την παρούσα εξώδικη απάντησή μας στην ίδια θέση και με την ίδια προβολή στην εφημερίδα σας στο επόμενο φύλλο της 10ης/9ου-2017. Σε αντίθετη περίπτωση θα καταθέσουμε εναντίον σας μήνυση και αγωγή αποζημίωσης για την τεράστια ηθική βλάβη που έχουμε υποστεί από την δημοσίευση του ψευδούς και συκοφαντικού δημοσιεύματός σας.
Πύργος 4-9-2017
Ο απαντών και διαμαρτυρόμενος
Γεράσιμος (Μάκης) Παρασκευόπουλος ..».